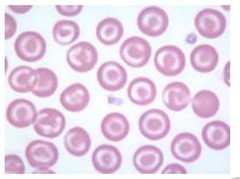

To Be Healed Very Rapidly
After exposure to TETANUS toxin, BOTULINUM toxin, HBV, VARICELLA, and RABIES virus, patients are given preformed antibodies (passive immunity)
You can drink BEER at the BAR when you’re 21
B cells, EBV, and CD21 *CD21 on B cell is the EBV receptor
Hot T-Bone stEAK
IL1 - fever (hot) IL2 - stimulates T cells IL3 - stimulates BONE marrow IL4 - stimulates IgE production IL5 - stimulates IgA production IL6 - stimulates aKute-phase protein production
Clean up on aisle 8
Neutrophils are recruited by IL8 to clear infections
Fab
Fragment, Antigen Binding
Fc
- Constant 2. Carboxy terminal 3. Complement binding 4. Carbohydrate side chains
There are 4 walls in a “rheum”
DR4 is HLA subtype for RHEUMatoid arthritis
PAIR
B27 is HLA subtype for: -Psoriatic arthritis -Ankylosing spondylitis -arthritis of Inflammatory bowel disease -Reactive arthritis (aka Reiter Syndrome)
SHiNE SKiS
Encapsulated bacteria: -Strep pneumo -Haem Influ -Neisseria meningitidis -E. coli -Salmonella -Klebsiella -Group B Strep
Need PLACESS
catalase positive bacteria: -Nocardia -Pseudomonas -Listeria -Aspergillus -Candida -E. coli -S. aureus -Serratia
“HALT” said the huntress to her TARGET.
See TARGET cells in: -HbC disease -Asplenia -Liver disease -Thalassemia
I ate 10 eggs at 12
T8 vena cava T10 “oesophagus” T12 aortic hiatus
Can’t Make New Blood Cells Properly
Carbamazepine
Methimazole
NSAIDs
Benzene
Chloramphenicol
Propythiouracil
-these drugs cause Aplastic Anemia
these drugs Cause Pretty Major Collapse To Defense Cells
Carbamazepine
Propylthiouracil
Methimazole
Clozapine
Ticlopine
Dapsone
Colchicine
-these drugs cause Agranulocytosis


